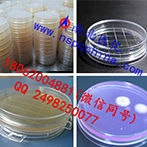

- 甘肃接触碟,南北医...
- DATE:2017-06-01 南北医化(图)|接触碟批发|甘肃接触碟由黑马计划官网提供。南北...
- [2017-06-01]甘肃接触碟,南北医化(在线咨询...
- [2017-06-01]黑龙江接触碟|接触碟批发|南北...
- [2017-06-01]广州液体取样器、不锈钢液体采...
- [2017-06-01]海口取样器_活塞取样器_南北医...
- [2017-06-01]上海抽样器_粉料抽样器_武汉南...
- [2017-06-01]北京取样器|颗粒物取样器|武汉...
- 橡胶瓶塞在药品包装...
- DATE:2017-05-27 药品包装工业使用橡胶的历史与橡胶工业一样古老。从早期的橡胶工业到现代橡...
- [2017-05-27]橡胶瓶塞在药品包装中的应用
- [2017-05-27]有机玻璃降尘缸的详细介绍
- [2017-05-27]圆形酸缸的简单介绍
- [2017-05-27]有机玻璃采水器用途多样
- [2017-05-27]CFDA发布医疗器械生产质量管理...
- [2017-05-27]食品药品监管总局关于进一步加...